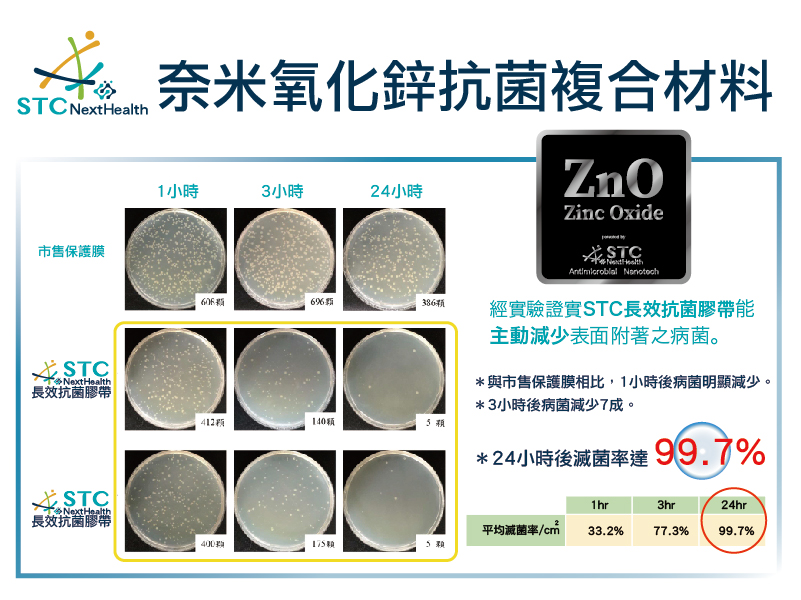

產品特色
Features
產品規格
Specification
購物說明
Product manual
檔案下載
Download
*膠帶表面塗佈奈米粒徑氧化鋅複合抗菌材料,能主動有效減少表面附著之病菌。
*對環境與人體友善無害,安全無毒配方,通過生物毒性測試不刺激不殘留。
*撕除離型紙後貼附在多人觸摸的物體表面可長效抗菌,切移除後無痕不殘膠。
*透明度高達90%,貼附在告示牌或電梯面板上不會影響閱讀。
*膠帶表面用清水或酒精等中性清潔劑擦拭後依然有抗菌效果。
*為確保膠帶抗菌效果,請1個月更換一次。
*如使用於人潮眾多之公共空間,例如車站、賣場等,請每個月更換一次。

使用方法
1.將欲貼抗菌膠帶之表面,清潔乾淨。
2.將抗菌膠帶裁剪至適合大小。
3.撕除離型紙及貼附完成。
(註:如擔心貼不平,可在欲貼表面先噴一點水,貼完抗菌膠帶後,將水推掉後,靜置到水乾即完成。)
注意事項
1.抗菌膠帶破損請盡早更換。
2.因抗菌膠帶屬於消耗品,除商品本身瑕疵外,故拆封使用後不接受退貨。
3.使用上有出現身體不適、過敏症狀,請立即停止使用。
4.膠帶表面印刷STC LOGO是為讓您更好辨別抗菌面。
追加配件
Fitting















